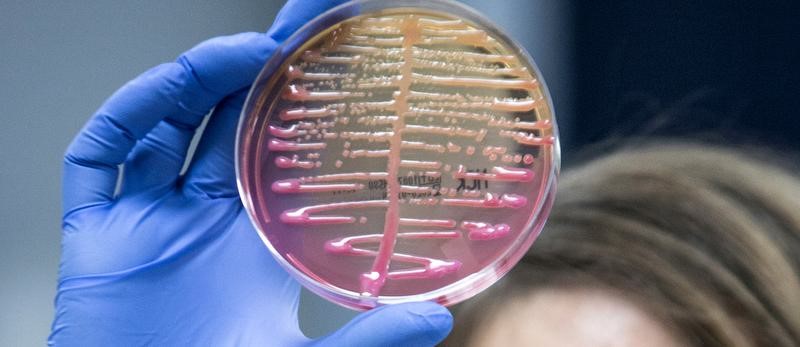

Description

Source:
Hindu
Disclaimer: Copyright infringement not intended.
Context
- Researchers at Columbia University have found that K. pneumoniae bacteria, when infected by bacteriophages, use reverse transcriptase to create a specific protein named Neo.
- This protein can halt bacterial cell replication, effectively stopping the infection.
Details
The Role of Reverse Transcriptase in Diagnostics and Research
- Significance During COVID-19: Reverse transcriptase became crucial in detecting SARS-CoV-2, aiding in rapid and accurate testing.
- Historical Discovery: Independently discovered by researchers Howard Temin and David Baltimore in 1970, reverse transcriptase showed that RNA could reverse-transcribe into DNA, challenging the Central Dogma of molecular biology.
- Impact: Revolutionized molecular biology research and diagnostics by allowing the creation of DNA from RNA, facilitating the study and treatment of RNA viruses like hepatitis B and HIV.
Retroelements in the Human Genome
- Role of Reverse Transcriptases: Significant in shaping the human genome through retroelements, sequences that originated from retroviruses.
- Horizontal Gene Transfer: Retroelements were transferred across species, not just from parent to offspring, impacting human biology and evolution.
- Recent Research: Studies show that human endogenous retroviruses, a class of retroelements, could be linked to neuropsychiatric diseases.
Reverse Transcriptase in Bacteria
- Discovery: The first bacterial reverse transcriptase was discovered in 1989.
- Types of Retroelements: Group II introns, retrons, and diversity generating retroelements in bacteria function similarly to those in humans.
Klebsiella pneumoniae and Bacteriophages
- Mechanism: When infected by bacteriophages, K. pneumoniae uses non-coding RNA with specific motifs to bind reverse transcriptase, creating DNA copies with the gene for Neo protein.
- Function of Neo Protein: Puts the bacterial cell in suspended animation, blocking replication and stopping bacteriophage infection.
Potential Applications
- Biotechnology and Medicine: The role of reverse transcriptase in bacterial defense against bacteriophages opens up new possibilities for combating antimicrobial resistance.
- Innovative Applications: Further research could lead to new therapeutic strategies and biotechnological tools, revealing novel mechanisms of genetic evolution and viral resistance.
Klebsiella pneumoniae Bacteria
- Klebsiella pneumoniae is a Gram-negative, rod-shaped bacterium commonly found in the human intestines where it generally does not cause harm. However, it can lead to severe infections, particularly in healthcare settings.
- Importance: This bacterium is significant due to its role in nosocomial (hospital-acquired) infections and its increasing resistance to multiple antibiotics.
- Capsule: Produces a prominent polysaccharide capsule, which is a key virulence factor.
- Oxygen Requirement: Facultative anaerobe

Habitat and Transmission
- Natural Habitat: Human gastrointestinal tract, respiratory tract, and various environmental sources such as soil and water.
- Transmission: Primarily through direct contact with contaminated surfaces, medical equipment, or person-to-person in healthcare settings. It can also spread through respiratory droplets.
Infections Caused
- Pneumonia: Particularly in hospitalized patients or those with weakened immune systems.
- Urinary Tract Infections (UTIs): Common in catheterized patients.
- Septicemia: Bloodstream infections that can lead to sepsis.
- Wound Infections: Including surgical site infections.
- Liver Abscesses: Particularly in individuals with diabetes or alcohol abuse.
Antibiotic Resistance
- Mechanisms of Resistance:
- Beta-Lactamase Production: Enzymes that break down beta-lactam antibiotics (e.g., carbapenemase, ESBL - Extended-Spectrum Beta-Lactamase).
- Efflux Pumps: Remove antibiotics from bacterial cells.
- Modification of Target Sites: Changes in the bacterial cell that prevent antibiotic binding.
- Multidrug-Resistant Strains: Carbapenem-resistant Klebsiella pneumoniae (CRKP) and other strains resistant to multiple antibiotic classes are major public health concerns.
Sources: Hindu
|
PRACTICE QUESTION
Q. The discovery of reverse transcriptase and its application in K. pneumoniae's defense against bacteriophages represents a significant advancement in our understanding of molecular biology. Comment. (250 Words)
|